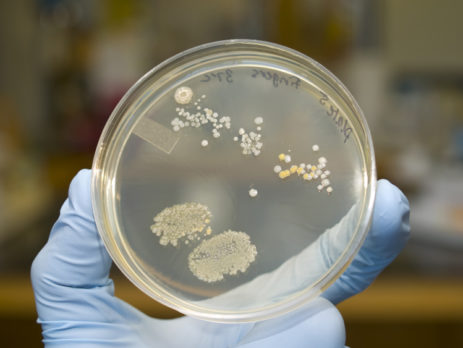

Hidden Sugars & Inflammatory Grains
Conventional advice has focused on low-fat diets for weight loss and heart disease prevention, but again and again, researchers are confirming that refined carbohydrates from sugars and grains is the primary culprit behind skyrocketing obesity rates, along with related diseases such as diabetes, heart disease and cancer. Historical data also clearly shows that when indigenous cultures abandon their traditional diets for a Western style diet high in sugar and flour, they inevitably begin to suffer these health problems, even [...]